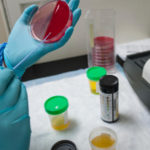
Colore della pipì in test di laboratorio medici esami delle urine

Il sistema solare è il sistema planetario costituito da una varietà di corpi celesti mantenuti in orbita dalla forza di gravità del Sole; vi appartiene anche la Terra.
È costituito, oltre che dal Sole, da otto pianeti (quattro pianeti rocciosi interni e quattro giganti gassosi esterni), dai rispettivi satelliti naturali, da cinque pianeti nani (tra cui l’ex pianeta Plutone) e da miliardi di corpi minori, tra cui comete e asteroidi.
Ci sono quasi 180 satelliti naturali nel sistema solare: Giove e Saturno ne detengono il primato, con più di 60 a testa, seguono poi Urano con 27, Nettuno con 13, Marte 2, la Terra 1 e Venere e Mercurio 0. Anche Plutone ha dei satelliti, il più massiccio dei quali, Caronte, ha una massa di sole 9 volte minore del pianeta (nano) intorno cui orbita: per un confronto, la Terra ha circa 81 volte la massa lunare. Ma di tutti questi satelliti qual è il più grande?
Pagina successiva per la top 10.